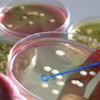

Iscriviti alla nostra newsletter
Newsletter n.3-4/16 - Dicembre 2016
di Pietro Cernigliaro
Presidente ANDMI
Nasce “Made in Rete”. Il 16 novembre 2016 è stata costituita l’Associazione di categoria, promossa da Confagricoltura che riunisce le imprese agricole alimentari, agroalimentari e agroindustriali.
Nell’agroalimentare sono stati stipulati ad oggi circa 450 contratti, che hanno coinvolto circa 2 mila imprese.
Il Presidente dell’Associazione, Marco Caprai, ha detto: “ siamo convinti che per crescere ed aumentare la propria competitività, l’agroalimentare debba fare network, superando i confini tra i vari comparti, al fine di realizzare un sistema più moderno e innovativo.
di Pietro Cernigliaro
Presidente ANDMI
Nella Sentenza n. 21937 del 28 ottobre 2016 (Corte di Cassazione), i Giudici di legittimità affermano che, nel caso in cui “ nel regime del lavoro pubblico contrattualizzato, in caso di abuso del ricorso al contratto di lavoro a tempo determinato da parte di una Pubblica Amministrazione, il dipendente, che abbia subito la illegittima precarizzazione del rapporto di impiego, ha diritto, fermo restando il divieto di trasformazione del contratto di lavoro da tempo determinato a tempo indeterminato posto all’art, 36,comma 5, del Dlgs. n. 165/01, al risarcimento del danno previsto dalla medesima disposizione…..
di Pietro Cernigliaro
Presidente ANDMI
Il 17 novembre 2016, l’Accademia dei Georgofili ha ospitato Mipaaf (Ministero delle Politiche Agricole), Crea (Consiglio per la ricerca in agricoltura e l’analisi dell’economia) e Clan (Cluster tecnologico agrifood nazionale), per presentare l’innovazione nell’agroalimentare italiano nei prossimi tre anni, tra biotecnologie sostenibili e agricoltura di precisione.